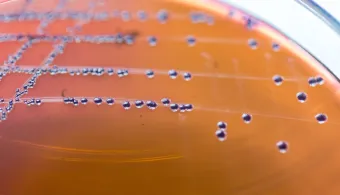

塑料抗菌效果由何决定?这篇文章带您认识抗菌添加剂
2025年12月17日
想象这样一个世界:医院、厨房乃至户外环境中的物体表面都能抑制微生物滋生。通过在塑料配方中添加抗菌剂,这一愿景即可成为现实。
抗菌塑料是通过添加功能性添加剂或涂层而制成的工程材料,旨在抑制或杀灭细菌、真菌和霉菌等微生物。其主要目标是创建能抵抗微生物定植的表面和产品。因此,在卫生至关重要的众多行业中,它们都展现出显著优势。
但抗菌塑料究竟如何工作?奥秘在于分子层面,不同类型的抗菌添加剂在此发挥作用。抗菌材料可以是天然、合成或半合成的。根据其作用范围,这些添加剂可大致分为两类:
广谱型:对多种微生物均有效;
窄谱型:针对特定类型的微生物。
无论是保护食品免于腐败,还是防止医疗机构中的感染传播,这些添加剂正在彻底改变我们对卫生和产品耐久性的认知。
抗菌添加剂的类型
抗菌添加剂并非“一体适用”。不同的应用场景和目标微生物需要不同的添加剂。以下章节将揭示抗菌添加剂的不同类别。
有机抗菌添加剂
有机抗菌添加剂在广泛的应用和产品中具有价值。然而,将其掺入注塑塑料制品时,效果有限。有机抗菌剂是相对较小的分子,与聚合物基体相容性不佳。因此,分子会迁移至产品表面,在那里与微生物相互作用,阻止其繁殖。这通常被称为抑菌效应。
迁移现象限制了添加剂的有效寿命,特别是在经常清洁的表面上,这导致其主要用于消耗品和一次性产品。它还会导致产品变色,并在涉及食品和水接触的应用中产生不良味道。有机抗菌剂对高加工温度敏感,这使其难以成功融入热塑性材料。
有机抗菌添加剂示例
有机抗菌剂包括但不限于:
酚类化合物
异噻唑啉酮处理剂
噻苯达唑
吡啶硫酮锌
碘丙炔醇丁基氨基甲酸酯
季铵盐化合物
10,10′-氧联二酚氧砷(OBPA)
基于砷的OBPA杀菌剂曾因其低成本和抗菌有效性而受青睐。如今,由于未列入欧盟生物杀灭剂产品法规清单,OBPA不能在欧洲使用。此外,美国环境保护署目前正在审查OBPA。因此,新一代更新、更环保且同样有效的抗菌选择已被开发出来以替代OBPA。
无机抗菌添加剂
无机抗菌剂更有可能被掺入注塑塑料制品中。许多此类添加剂基于金属离子,这些离子在与水分等其他介质作用释放前不具反应活性。这些抗菌剂储存在聚合物内部,逐渐释放到表面,提供持续、长效的保护。这类添加剂兼具杀菌和抑菌效果。
无机抗菌添加剂示例
锌和银在低浓度下具有强抗菌活性,但需要较高浓度才能达到足够的抗真菌性能。
沸石是多孔陶瓷基材料,含有锌等多种抗菌离子。这些材料适用于短期使用(5-10年),对一次性/有限次使用产品很有用。
不同活性物质的协同组合可以降低总体抗菌剂用量、节省成本并提供卓越的抗菌性能。
如何对聚合物产品进行抗菌处理?
抗菌处理可通过在产品表面涂层或在制造过程中内添加的方式应用于聚合物产品。将抗菌添加剂融入塑料主要有两种方法。
母粒
母粒是抗菌添加剂与载体树脂的浓缩混合物,可在制造过程中添加到基础聚合物中。
加工过程添加
抗菌添加剂也可在挤出或注塑等加工过程中直接添加到聚合物中。这涉及在塑料产品成型前将添加剂与熔融聚合物混合。例如,在制造过程中将抗菌添加剂加入聚合物中,可使乙烯基材料抵抗微生物生长(图1)。这既保持了美观和拉伸强度,又延长了PVC产品的最终使用寿命。

图 1:未经处理的 PVC(左)和经抗菌处理的 PVC(右),采用 ASTM G21 2标准进行测试
抗菌塑料的工作原理是什么?
抗菌添加剂可以类似的方式对抗细菌、真菌和藻类。一些常见的作用模式总结如下:
活性氧生成:暴露于金属氧化物等材料后会产生ROS,例如超氧阴离子、羟基自由基和过氧化氢。这些ROS可诱导细菌细胞中多不饱和磷脂的过氧化,从而损伤DNA,最终导致细胞死亡。
物理损伤:微生物的细胞壁膜在与纳米结构材料的锋利边缘相互作用时可能受损。抗菌添加剂通过破坏微生物的细胞功能来发挥其作用。
结合作用:结合在细菌细胞壁上的材料可导致细胞膜完整性丧失和细胞质内容物外流。
释放金属离子:从纳米材料释放到培养基中的金属离子可以抑制ATP产生和DNA复制,从而破坏细胞。

图2:金属离子抗菌机制示意图
针对细菌的特定作用模式
图 2 以示意图的形式概述了抗菌添加剂(尤其是金属离子抗菌添加剂)可能的杀菌机制。例如,银离子可以与微生物 DNA 结合,阻止其复制并导致细胞死亡。这使得银基添加剂在各种应用中都非常有效,例如医疗器械和消费品。
根据抗菌添加剂的作用方式,它们可分为两类:
杀菌:杀菌技术会导致细胞不可逆死亡。医疗机构中,为了维持无菌环境,通常会选择杀菌技术来处理相关材料。
抑菌剂:抑菌剂与杀菌剂的区别在于,抑菌剂抑制细菌细胞的生长和繁殖,而不是直接杀死细菌。
抗菌添加剂会干扰细菌的细胞功能。一项研究旨在检验耐甲氧西林金黄色葡萄球菌(MRSA)对塑料样品的抗菌效果。研究人员向添加和未添加抗菌添加剂的样品中添加了相同数量的细菌,然后在37°C(体温)下孵育24小时。

图3:从未经处理的塑料中分离出的耐甲氧西林金黄色葡萄球菌(左);从抗菌塑料中分离出的耐甲氧西林金黄色葡萄球菌(右),均按照 ISO 20743 标准2进行测试
如图3所示,从未经处理的塑料中回收了大量细菌(图3左图)。相比之下,从添加抗菌剂的塑料中回收的细菌数量极少(图3右图)。
因此,在分子水平上理解这些添加剂的功能对于认识其有效性至关重要。
抗菌添加剂在聚合物应用中的效果
抗菌添加剂在聚合物中的有效性取决于几个关键因素,根据ISO 22196标准⁵进行测量。
微生物类型
不同的抗菌剂对不同微生物表现出不同程度的功效。例如:
Bactericides:可能对细菌特别有效
Fungicides:对真菌有效
Algaecides:对藻类有效
聚合物类型
抗菌剂与聚合物基体之间的相容性对于实现最佳性能至关重要。某些聚合物可能比其他聚合物更容易接受特定的抗菌剂,这会影响抗菌剂在材料内的分布和活性。
添加剂浓度
掺入聚合物中的抗菌剂量影响其抗菌活性。通常,浓度越高,抗菌保护作用越强。然而,过量添加可能会损害聚合物的其他性能。
加工条件
制造过程会影响抗菌剂在聚合物内的分布和活性。温度、压力和混合时间等因素会影响抗菌剂的分散性以及抑制微生物生长的有效性。
耐久性
抗菌添加剂必须具有耐久性,以长期保持其有效性。在正常使用条件下,它们不应降解或丧失抗菌性能。
法规符合性
抗菌添加剂必须符合相关的监管标准,尤其是在医疗保健和食品加工等行业。这些标准可能因具体应用和抗菌聚合物的预期用途而异。
抗菌塑料的跨行业应用
在许多工业应用中,聚合物必须承受高温。这对抗菌添加剂提出了独特挑战,因为它们需要在此类条件下保持其有效性。为满足这一需求,已开发出多种用于高温聚合物应用的抗菌添加剂⁴。
季铵盐化合物:QACs因其广谱活性和相对较低的毒性而被广泛用作抗菌剂。某些QACs可以在高温下保持其有效性。
银:银的抗菌特性早已得到认可。银基抗菌剂适用于高温加工应用和透明级塑料,例如聚碳酸酯。
锌:氧化锌是另一种可用于高温应用的无机抗菌剂,常与其他添加剂结合使用以增强其效果。
结论
抗菌添加剂已成为我们追求更清洁、更安全、更耐用产品的强大解决方案。抗菌塑料是配备特殊添加剂或涂层的工程材料,能够抑制或杀死细菌、真菌和霉菌等微生物。
这些添加剂可以是有机或无机的,针对多种微生物。它们用于医疗保健、食品加工、纺织品和户外应用等多个行业。
这些塑料通过破坏微生物的细胞功能来发挥作用。例如,银离子可以阻止细菌繁殖,导致细胞死亡。其结果是改善了卫生状况、降低了感染风险、延长了产品寿命并增强了产品性能。
然而,抗菌塑料的有效性取决于多种因素,包括所用添加剂的类型、聚合物材料和制造工艺。在某些行业(如医疗保健和食品加工)中,其使用也受到法规监管。虽然它们提供了宝贵的解决方案,但考虑其环境影响和潜在局限性也很重要。


